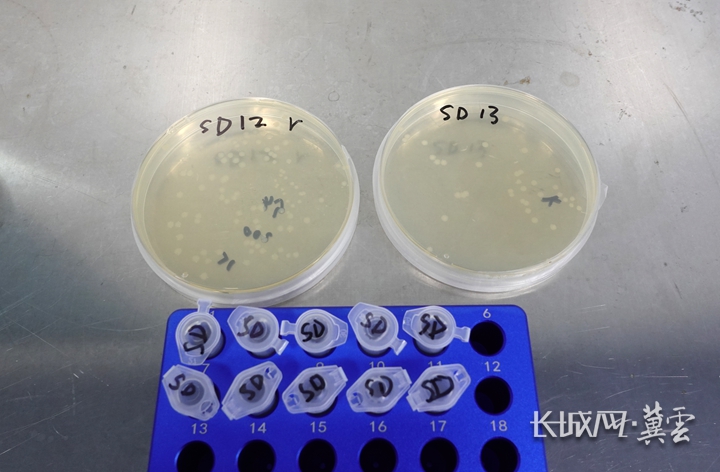

開局看“未來”② | 植入“基因密碼” 細(xì)菌變身“人源蛋白制造機(jī)”
“養(yǎng)殖”億萬個(gè)微小生命,讓它們?yōu)槟闵a(chǎn)價(jià)值堪比黃金的生命蛋白,這聽起來是不是有點(diǎn)“科幻”?在石家莊國(guó)家高新技術(shù)產(chǎn)業(yè)開發(fā)區(qū)的河北納科生物科技有限公司(簡(jiǎn)稱“納科生物”),這已經(jīng)成為現(xiàn)實(shí)。
這里“養(yǎng)殖”的經(jīng)過基因改造的細(xì)菌——正默默變身為人源功能性蛋白的“制造機(jī)”。
基因“編輯”:AI賦能的分子級(jí)“微創(chuàng)手術(shù)”
納科生物是一家AI賦能利用合成生物學(xué)技術(shù)制造功能性蛋白的國(guó)家高新技術(shù)企業(yè)。
4月13日下午,記者走進(jìn)納科生物的發(fā)酵車間,映入眼簾的是一套密布管線和儀表的自動(dòng)化發(fā)酵系統(tǒng)。納科生物發(fā)酵技術(shù)員王亞南正通過顯示屏上的參數(shù),觀察著他“養(yǎng)殖”的小生命。

納科生物發(fā)酵技術(shù)員王亞南正通過顯示屏上的參數(shù),觀察著他“養(yǎng)殖”的小生命。 長(zhǎng)城網(wǎng)?冀云客戶端記者 鄭建衛(wèi) 攝
發(fā)酵系統(tǒng)里裝著的是褐色如奶茶般的液體,每毫升藏著100億到1000億個(gè)細(xì)菌!這些小家伙小到什么程度?80到100個(gè)并排站在一起,才抵得上一根頭發(fā)絲的粗細(xì)。可別小看它們,這些經(jīng)過基因編輯的“微型工人”,正忙著把吸收的營(yíng)養(yǎng)物質(zhì)轉(zhuǎn)化成人源三型膠原蛋白。
“1千克最高級(jí)別的醫(yī)用人源三型膠原蛋白,價(jià)值可達(dá)100萬元以上,和24K黃金的價(jià)格相當(dāng)!”納科生物總經(jīng)理徐蘭舉介紹。

納科生物總經(jīng)理徐蘭舉向記者介紹生物制造的原理。長(zhǎng)城網(wǎng)?冀云客戶端記者 鄭建衛(wèi) 攝
為什么這么貴?因?yàn)椤罢滟F”。人源三型膠原蛋白的氨基酸序列與人體自身產(chǎn)生的膠原蛋白幾乎完全一致,完美解決了傳統(tǒng)動(dòng)物源膠原蛋白的三大痛點(diǎn):排異反應(yīng)、病毒風(fēng)險(xiǎn)和水解吸收率低。
在醫(yī)療領(lǐng)域,它能促進(jìn)人體組織再生;在醫(yī)美護(hù)膚界,它是增強(qiáng)皮膚彈性、抗皺抗衰老的“神器”。極高的技術(shù)門檻、昂貴的生產(chǎn)成本,加上卓越的功能效果和龐大的市場(chǎng)需求,讓它成為生物制造領(lǐng)域的“皇冠明珠”。
這些小小的細(xì)菌為啥能夠“生產(chǎn)”人類蛋白?這要從一場(chǎng)分子層面的“微創(chuàng)手術(shù)”說起。
首先,技術(shù)人員利用AI輔助設(shè)計(jì)制造出攜帶人源三型膠原蛋白遺傳信息的“密碼子”。然后,將這些人類“密碼子”注入細(xì)菌的細(xì)胞中,讓它們成為“人類功能性蛋白制造專家”。
說來簡(jiǎn)單,但這一步卻難如登天——“手術(shù)”成功率不到千分之一!向1千萬到1億個(gè)細(xì)菌中注入“密碼子”,最終只有1萬到10萬個(gè)“幸運(yùn)兒”能成功接納人類遺傳密碼。
圓形培養(yǎng)皿中的白色斑點(diǎn),就是“手術(shù)成功”的菌株。長(zhǎng)城網(wǎng)?冀云客戶端記者 鄭建衛(wèi) 攝
接下來,技術(shù)人員要像淘金一樣,從數(shù)萬細(xì)菌中篩選出那些“手術(shù)成功”的菌株,作為“種子”小心翼翼地保存在-80°C的甘油管中。
發(fā)酵“牧場(chǎng)”:從微小菌種到百億大軍
制造“密碼子”、實(shí)施“手術(shù)”、篩選成功者——每一步都必須在嚴(yán)格的環(huán)境參數(shù)下進(jìn)行,技術(shù)門檻之高,堪稱生物制造領(lǐng)域的“珠穆朗瑪峰”。
當(dāng)需要生產(chǎn)時(shí),工作人員會(huì)取出一管保存好的菌種,讓它們?cè)谂囵B(yǎng)液中“蘇醒”并快速增殖。一旦數(shù)量達(dá)標(biāo),這些“種子菌株”就會(huì)被投入發(fā)酵系統(tǒng),開始它們的“職業(yè)生涯”。
發(fā)酵系統(tǒng)好比一座“細(xì)菌牧場(chǎng)”,環(huán)境被嚴(yán)格控制,確保細(xì)菌在最適宜的條件下快速生長(zhǎng)。它們每20到30分鐘就分裂一次,72小時(shí)后,每毫升發(fā)酵液里擠滿了100億到1000億個(gè)帶著人類遺傳密碼的細(xì)菌。此時(shí),它們的“體內(nèi)”已經(jīng)積累了珍貴的人源三型膠原蛋白。
但把這些人源三型膠原蛋白提取出來,才是真正的高難度挑戰(zhàn)。
透過提純車間的玻璃窗,可以看到一排排不銹鋼罐,發(fā)酵液在這里經(jīng)歷菌體粉碎、離心分離等一系列復(fù)雜工序,人源三型膠原蛋白的純度一步步提升。然后,來到最難的一關(guān):蛋白質(zhì)折疊。

保存的菌種在這些設(shè)備中蘇醒和增殖。長(zhǎng)城網(wǎng)?冀云客戶端記者 鄭建衛(wèi) 攝
“只有純度達(dá)到99%以上、并形成穩(wěn)定三螺旋結(jié)構(gòu)的人源三型膠原蛋白,才能應(yīng)用于臨床治療?!毙焯m舉說。
細(xì)菌生產(chǎn)出的人源三型膠原蛋白,最初并不具備在人體中發(fā)揮醫(yī)療功能所需的三螺旋結(jié)構(gòu)——就像一堆散亂的毛線,還沒有織成保暖的毛衣。只有在羥基酶的精準(zhǔn)調(diào)控下,這些蛋白才能“折疊”成正確的三螺旋結(jié)構(gòu),從而擁有生物活性。
這一步,如同在微觀世界里進(jìn)行一場(chǎng)精密的“編織藝術(shù)”,稍有差池,前功盡棄。目前,全球僅有少數(shù)幾家企業(yè)掌握這項(xiàng)核心技術(shù),而納科生物不僅攻克了難關(guān),還為此申請(qǐng)了多項(xiàng)專利。
未來“藍(lán)?!备哐邪l(fā)投入下的爆發(fā)式增長(zhǎng)
納科生物的成功,離不開一支高素質(zhì)的研發(fā)團(tuán)隊(duì),公司擁有碩士以上學(xué)歷的員工占比超過三分之一。2024年和2025年,企業(yè)的研發(fā)投入連續(xù)兩年超過年支出的53%。與此同時(shí),公司年產(chǎn)值也實(shí)現(xiàn)了連續(xù)兩年100%的驚人增長(zhǎng)。
近年來,納科生物已經(jīng)取得國(guó)家專利30項(xiàng),承擔(dān)政府科研項(xiàng)目23項(xiàng),參與蛋白類新材料國(guó)家行業(yè)標(biāo)準(zhǔn)制定3項(xiàng)。
“生物制造是國(guó)家未來產(chǎn)業(yè)重點(diǎn)培育的方向之一?!毙焯m舉說,“隨著老齡化社會(huì)的到來,對(duì)人源功能蛋白的需求將持續(xù)飆升。在政策支持和市場(chǎng)需求的雙重驅(qū)動(dòng)下,這個(gè)市場(chǎng)已進(jìn)入高速發(fā)展期。”
展望未來,納科生物已成功培育出系列菌種,更多新型人源功能性蛋白也將陸續(xù)投產(chǎn)。
生物制造是未來產(chǎn)業(yè)的核心引擎,被列為國(guó)家“十五五”前瞻布局的六大未來產(chǎn)業(yè)之一。河北省作為全國(guó)生物制造傳統(tǒng)強(qiáng)省,2023年率先發(fā)布全國(guó)首部生物制造產(chǎn)業(yè)發(fā)展藍(lán)皮書,構(gòu)建了以石家莊為核心,秦皇島、滄州協(xié)同發(fā)展的產(chǎn)業(yè)格局,依托“京津研發(fā)、河北制造”模式,正全力打造全國(guó)領(lǐng)先的生物制造產(chǎn)業(yè)高地。
來源:冀云
編輯:劉菡
責(zé)編:劉芳
編審:劉福慶
監(jiān)審:王勍